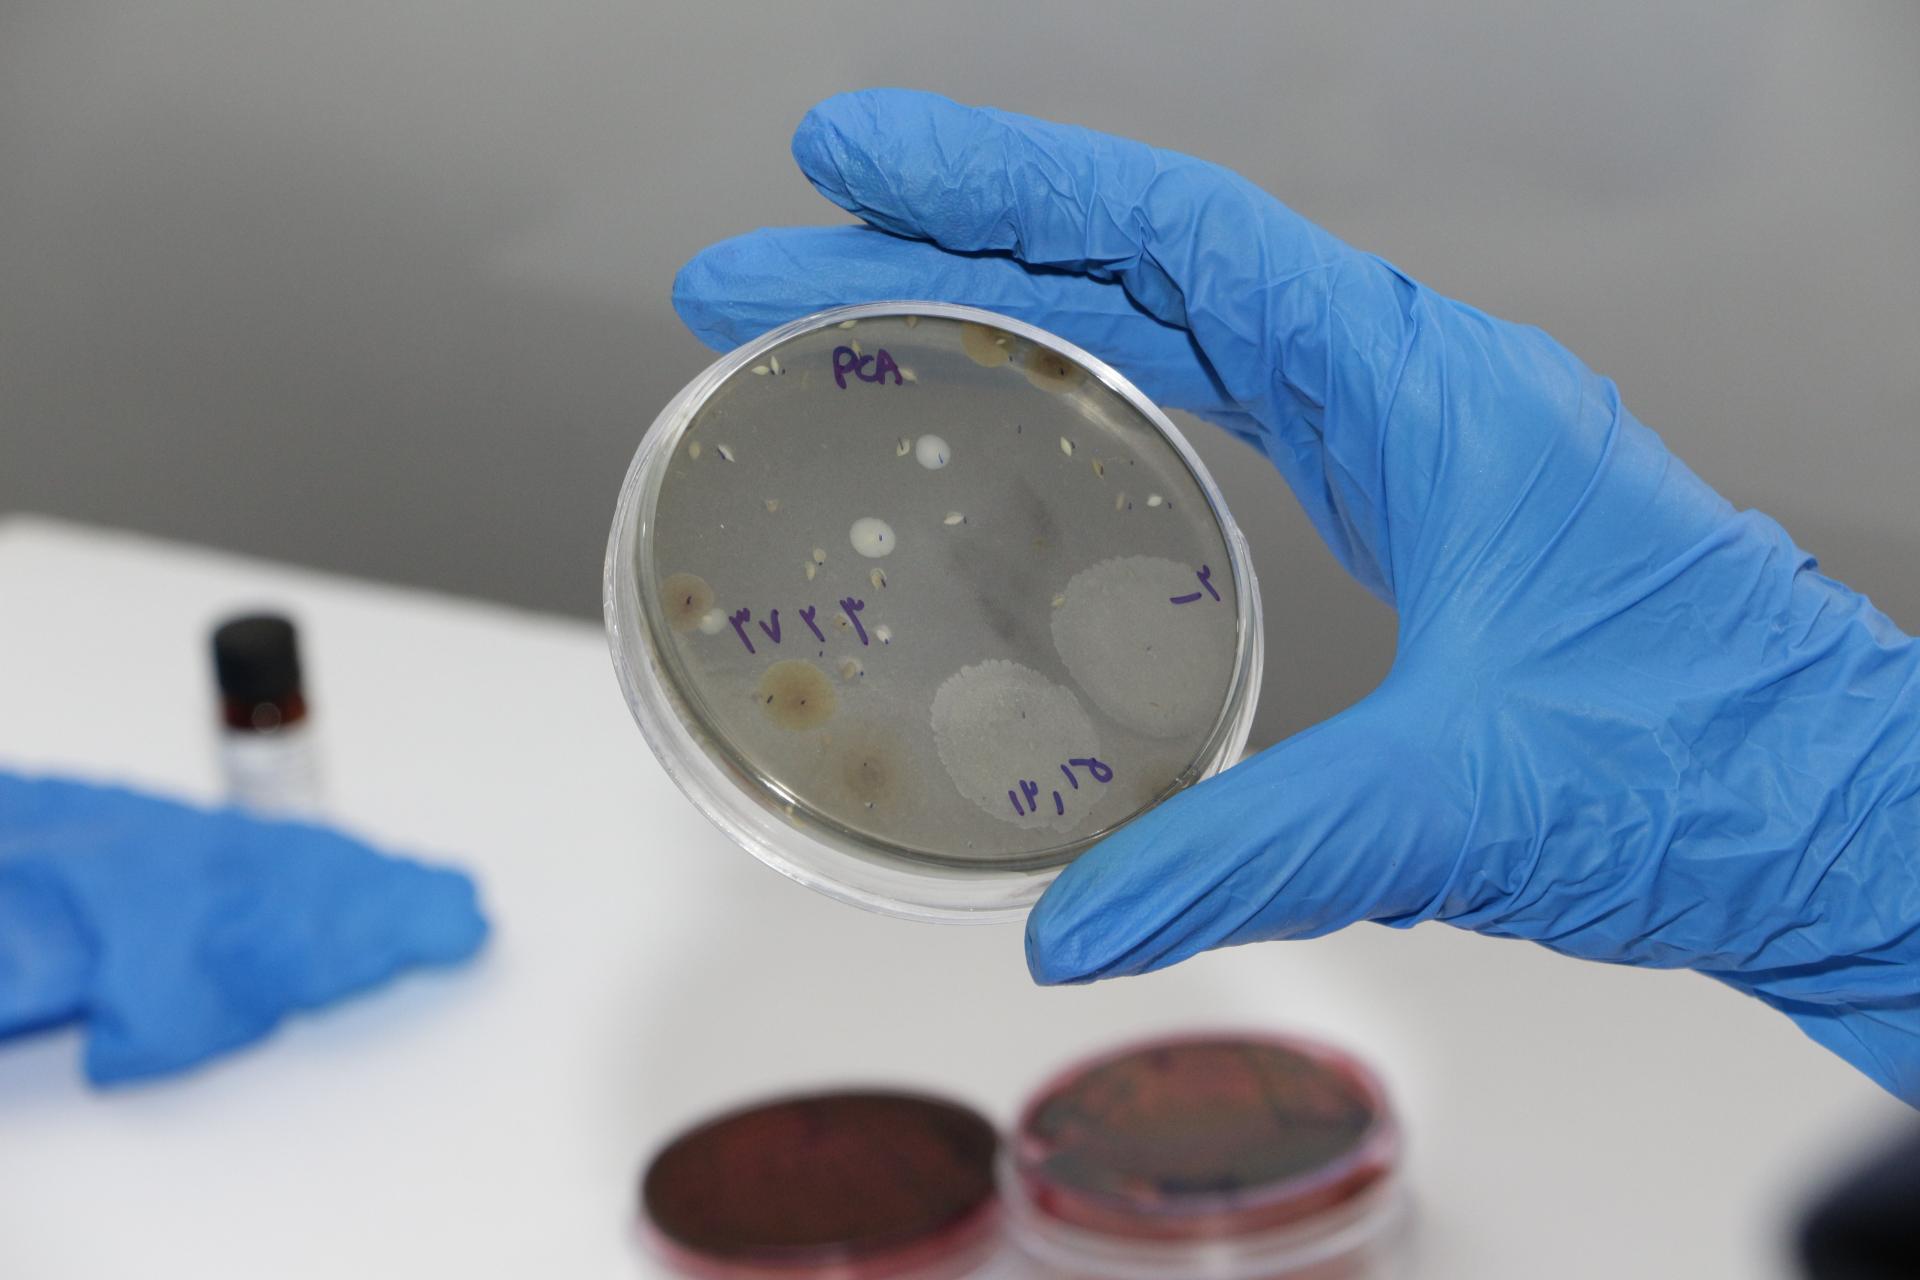
عکس آزمایشگاه تخصصی پرتو بشاش

©OpenStreetMap Contributors©Neshan
 شمال
شمال نمایش موقعیت من
نمایش موقعیت منآزمایشگاه زکریا
5/0



 3 رای
3 رای
آزمایشگاه تشخیص طبی
ﺑﻪ اﯾﻦ ﻣﮑﺎن اﻣﺘﯿﺎز دﻫﯿﺪ




- تهران
- /
- آزمایشگاههای تهران
- /
- آزمایشگاه زکریا
آزمایشگاههای پیشنهادی در نزدیکی آزمایشگاه زکریا
امکانات نزدیک
سرویس بهداشتی
خودپرداز
ایستگاه اتوبوس
دستهبندیهای مرتبط با آزمایشگاه زکریا
ﺑﻪ اﯾﻦ ﻣﮑﺎن اﻣﺘﯿﺎز دﻫﯿﺪ
دربارهی آزمایشگاه زکریا
آزمایشگاه زکریا (آزمایشگاه تشخیص طبی) در محله شهرک پرواز تهران و تهران، بزرگراه علامه جعفری، آیت الله کاشانی شرق، یکم غربی، اول شرقی، پلاک 2 واقع شده است. این مکان یکی از سه آزمایشگاه تشخیص طبی در محله شهرک پرواز تهران میباشد و از نظر موقعیت جغرافیایی در نزدیکی بازارچه نور و همچنین پارک پرواز، فرتاک سرویس، کارواش نانو کوروش، گل فروشی مینیاتور و آذرصبا نمایندگی ایران رادیاتور و بوتان قرار گرفته است. با توجه به نزدیکی این مکان به ایستگاه مترو علامه جعفری، برای دسترسی راحتتر و کمک به داشتن هوایی پاکتر، میتوانید از وسایل حمل و نقل عمومی برای مراجعه به آن استفاده کنید.